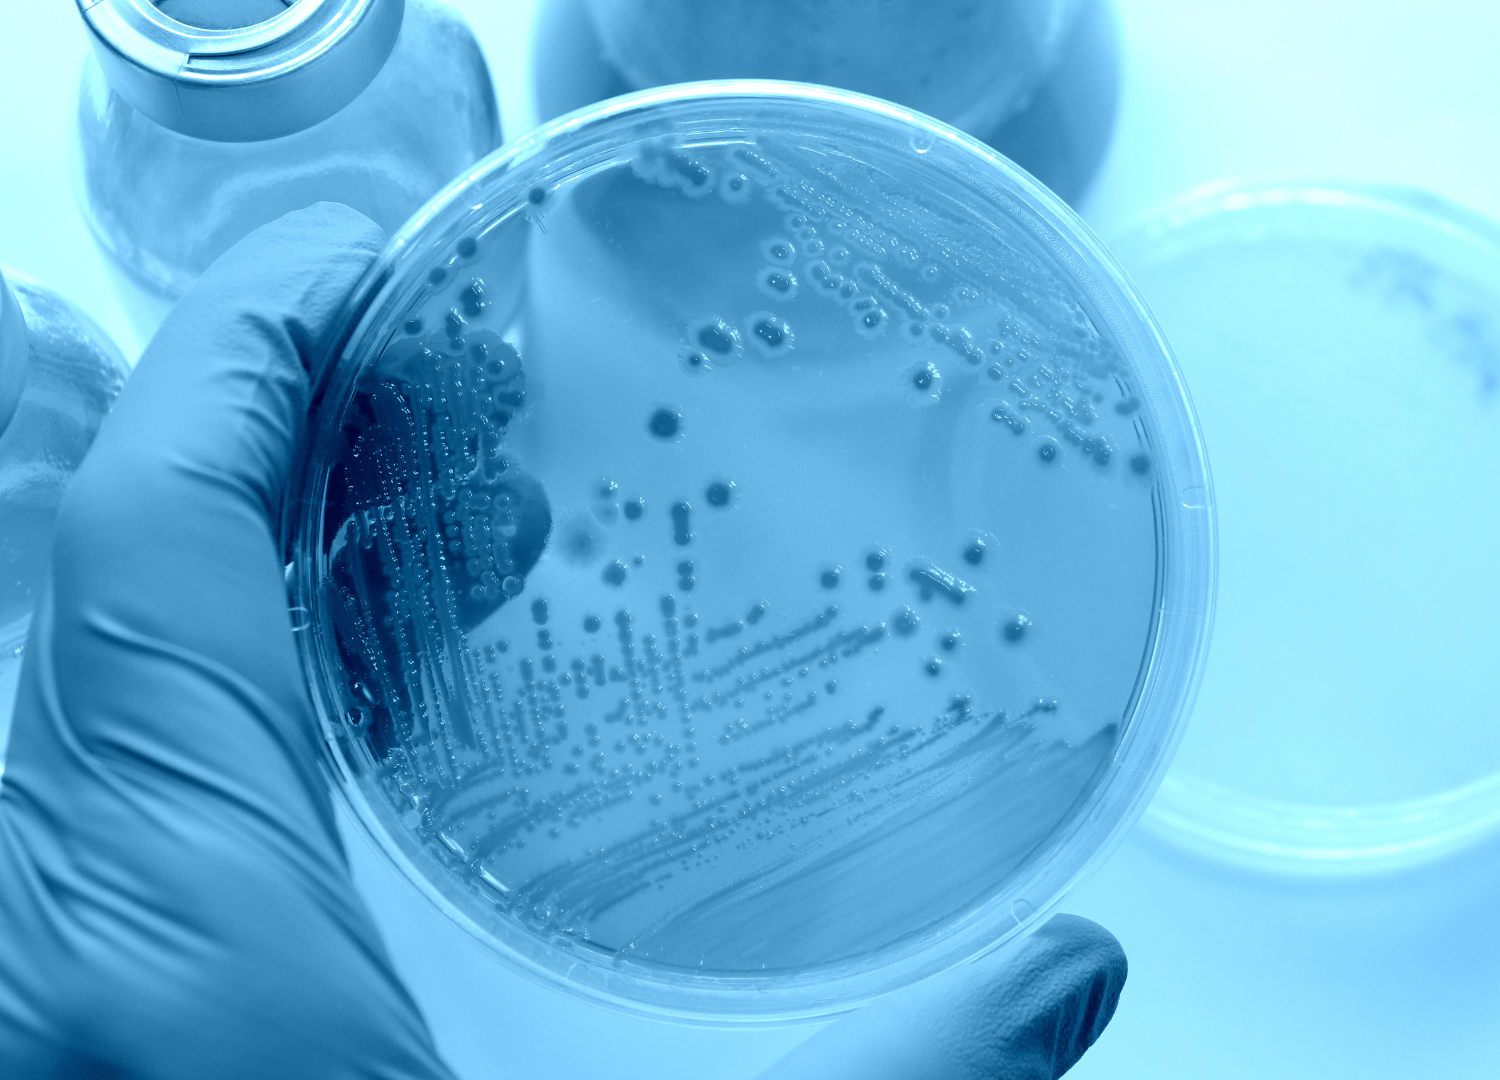
Topische Probiotika bei Neurodermitis: Warum der richtige Stamm entscheidend ist

Topische Probiotika bei Neurodermitis: Was die Forschung sagt – und warum der richtige Stamm entscheidend ist
Neurodermitis · Hautmikrobiom · Probiotische Pflege
Viele Kinder und auch Erwachsene kennen das: trockene, juckende, gerötete Haut, die den Alltag bestimmt. Gesucht wird etwas, das nicht nur „fettet“, sondern die Haut wieder ins Gleichgewicht bringt. Genau hier setzen topische Probiotika an. Das sind nützliche Bakterien, die direkt auf die Haut aufgetragen werden. Studien zeigen: Sie können das Zusammenspiel der Hautkeime verbessern und Entzündungen beruhigen.
Wichtig ist dabei ein Punkt, der oft übersehen wird: Nicht jedes Probiotikum wirkt gleich. Entscheidend ist der genaue Bakterienstamm.
In diesem Text erfährst du, was die Forschung dazu sagt, warum der Stamm so wichtig ist und wie unser patentangemeldeter Lanbiotic-Stamm in Tests und im Alltag abschneidet. Inzwischen nutzen über 10.000 Kund:innen unsere Pflege – dazu gleich mehr.
Inhaltsverzeichnis
- Was sind topische Probiotika bei Neurodermitis?
- Wirkmechanismen: Wie Probiotika auf der Haut helfen
- Warum sind topische Probiotika jetzt Trend?
- Einsatzmöglichkeiten und klinische Erfahrungen
- Lanbiotic-Stamm: Spezifische Vorteile für Neurodermitis
- Natürliche Unterstützung bei Neurodermitis mit topischen Probiotika
- Häufig gestellte Fragen
- Empfehlung
Wichtige Erkenntnisse im Überblick
| Punkt | Details |
|---|---|
| Topische Probiotika | Sie können das Gleichgewicht der Hautkeime verbessern, Entzündungen dämpfen und die Hautbarriere unterstützen. |
| Stamm-spezifische Wirkung | Die Effekte hängen stark vom konkreten Stamm ab. Manche Stämme verdrängen Problemkeime effektiv, andere kaum. |
| Lanbiotic-Stamm | Unser patentangemeldeter Stamm Lactococcus lanbioticus (wissenschaftlich: Lactococcus lactis LC10123) hat in Laborversuchen Staphylococcus aureus vollständig unterdrückt und zeigte in einer Studie Verbesserungen bei Barriere, Juckreiz und Hautzustand. |
| Klinische Anwendung | In einer 4-wöchigen, dermatologisch begleiteten Anwendung stiegen Hautfeuchtigkeit und Komfort deutlich, während Juckreiz und lokaler SCORAD sanken – bei sehr guter Verträglichkeit. |
| Alltag & Praxis | Steroidfrei, langfristig nutzbar und gut in Pflegeroutinen integrierbar – besonders sinnvoll, wenn der Stamm gezielt gegen S. aureus wirkt. |
1. Was sind topische Probiotika bei Neurodermitis?
Topische Probiotika sind Pflegeprodukte, die nützliche Bakterien oder deren aktive Bestandteile enthalten und direkt auf die Haut kommen – etwa als Creme, Lotion oder Spray. Ziel ist es, die Hautbarriere (die natürliche Schutzschicht) zu stärken und das Hautmikrobiom zu stabilisieren.
Mit Hautmikrobiom ist die Gesamtheit der Mikroorganismen auf der Haut gemeint. Bei Neurodermitis gerät dieses Gleichgewicht oft durcheinander. Häufig breitet sich der Problemkeim Staphylococcus aureus stärker aus, während „gute“ Keime fehlen. Probiotische Pflege versucht, dieses Ungleichgewicht zu korrigieren.
2. Wirkmechanismen: Wie Probiotika auf der Haut helfen
Vereinfacht gesagt wirken topische Probiotika über drei Wege, die sich gegenseitig verstärken. Sie können schädliche Keime verdrängen, die Hautbarriere dichter machen und Entzündungen beruhigen.
Bei vielen Menschen mit Neurodermitis spielt S. aureus eine wichtige Rolle. Dieser Keim treibt Entzündungen an und schwächt die Barriere. Ein wirksamer Probiotika-Stamm konkurriert mit diesem Keim um Platz und Nährstoffe und kann Stoffe bilden, die das Wachstum von S. aureus hemmen.
Gleichzeitig unterstützt der Stamm die Barrierefunktion. Die Haut verliert weniger Feuchtigkeit, bleibt im natürlichen pH-Bereich und reagiert weniger empfindlich. Auch das Immunsystem der Haut profitiert, was sich indirekt auf Juckreiz auswirken kann.
Wichtig ist: Diese Effekte sind nicht bei jedem Produkt gleich. Zwei Cremes mit „Probiotika“ auf dem Etikett können sehr unterschiedlich wirken – je nach eingesetztem Stamm und Formulierung.
3. Warum sind topische Probiotika jetzt Trend?
Zum einen hat die Forschung rund um das Hautmikrobiom in den letzten Jahren stark zugenommen. Wir verstehen besser, wie eng Barriere, Keime und Entzündung zusammenhängen. Zum anderen stoßen klassische Therapien an Grenzen: Kortison und ähnliche Wirkstoffe haben ihren Platz, sind aber nicht für die Daueranwendung gedacht und verändern das Mikrobiom nicht gezielt.
Viele Betroffene suchen deshalb eine steroidfreie, alltagstaugliche Ergänzung, die reguliert statt nur zu unterdrücken. Moderne Formulierungen machen das möglich: stabile, milde Cremes, die probiotische Bestandteile dorthin bringen, wo sie wirken sollen.
4. Einsatzmöglichkeiten und klinische Erfahrungen
Topische Probiotika eignen sich als tägliche Basispflege und als Begleitung zwischen oder nach akuten Schüben. Üblich ist die Anwendung ein- bis zweimal täglich auf die betroffenen Stellen. So lässt sich die Hautbarriere schrittweise stabilisieren und die Anfälligkeit für Reizungen senken.
Für unsere probiotische Pflege Lipid Care wurde eine 4-wöchige Anwendung unter dermatologischer Kontrolle durchgeführt. Teilgenommen haben 20 Erwachsene mit trockener, atopie-geneigter Haut. Gemessen wurden Hautfeuchtigkeit, der sogenannte TEWL und der lokale SCORAD-Wert.
TEWL bedeutet „transepidermaler Wasserverlust“. Das beschreibt, wie viel Feuchtigkeit ungewollt über die Haut verdunstet. Je niedriger dieser Wert, desto stärker ist die Barriere. Der SCORAD ist ein klinischer Schweregrad-Score für Neurodermitis. Er fasst sichtbare Hautveränderungen und Symptome wie Juckreiz zusammen.
Nach 4 Wochen zeigte sich:
- Die Hautfeuchtigkeit stieg um 98,5 %.
- Der TEWL sank um 17,9 %.
- Der lokale SCORAD verringerte sich um 25,5 %.
Der pH-Wert blieb im gesunden Bereich und die Verträglichkeit war sehr gut. Die Teilnehmenden berichteten von glatterer Haut, weniger Juckreiz und mehr Wohlbefinden im Alltag.
5. Lanbiotic-Stamm: Spezifische Vorteile für Neurodermitis

Der Kern unserer Formulierung ist unser patentangemeldeter Stamm:
Lactococcus lanbioticus
(wissenschaftlich: Lactococcus lactis LC10123)
5.1 Vom Labor…
In einem Vergleich im Labor wurde unser Stamm zusammen mit S. aureus in einem gemeinsamen System kultiviert und gegen einen bekannten Probiotika-Stamm (Lactobacillus rhamnosus) getestet. Nach 24 Stunden war S. aureus bei LC10123 nicht mehr nachweisbar. Beim Vergleichsstamm war S. aureus nur deutlich reduziert, aber weiterhin vorhanden.
Beide Probiotika blieben stabil – der Unterschied lag also in der gezielten Wirkung auf den Problemkeim.
5.2 …auf die Haut
In der oben beschriebenen Anwendung zeigte Lipid Care mit LC10123 messbare Verbesserungen bei Barriere (TEWL), Hautfeuchtigkeit und klinischen Zeichen (SCORAD) – bei sehr guter Verträglichkeit. Diese Daten passen zu unserer Alltagserfahrung: über 10.000 Anwender:innen nutzen die Pflege bereits.
Rückmeldungen häufen sich vor allem zu weniger Spannungsgefühl, weniger Aufkratzen und einem „ruhigeren“ Hautgefühl.
6. Natürliche Unterstützung bei Neurodermitis mit topischen Probiotika
Neurodermitis ist chronisch und vielschichtig zu, weshalb es einer ganzheitlichen Pflege bedarf. Eine einzelne Creme „heilt“ sie nicht. Aber du kannst deiner Haut helfen, stabiler zu werden. Probiotische Pflege ist steroidfrei, langfristig nutzbar und setzt am Kernproblem an: Barriere und Mikrobiom.
Unsere Lipid Care wurde genau dafür entwickelt – als tägliche Begleitung für trockene, sensible und neurodermitische Haut.
7. Häufig gestellte Fragen
Was sind topische Probiotika?
Topische Probiotika sind Pflegeprodukte mit nützlichen Bakterien oder deren Bestandteilen. Sie werden direkt aufgetragen, um das Hautmikrobiom zu stabilisieren, die Barriere zu stärken und Entzündungen zu beruhigen.
Wirken alle probiotischen Cremes gleich?
Nein. Die Wirkung ist stammabhängig. Unser Stamm Lactococcus lactis LC10123 konnte S. aureus im Labor vollständig unterdrücken; andere Stämme schaffen das nicht immer. Entscheidend ist, welcher Stamm in der Creme steckt und wie er mit der Haut interagiert.
Heilen topische Probiotika Neurodermitis?
Nein. Sie sind eine sinnvolle Ergänzung: bessere Barriere, weniger Juckreiz, spürbar mehr Hautkomfort. Ärztliche Diagnose und Therapie bleiben wichtig, besonders bei mittelgradiger und schwerer Neurodermitis.
Sind topische Probiotika für Kinder geeignet?
Der Ansatz ist auch für Kinder interessant, weil er steroidfrei ist. Achte auf milde Formulierungen und sprich bei ausgeprägter Neurodermitis mit der Kinderärztin oder dem Dermatologen, bevor du neue Produkte einsetzt.
Wie integriere ich probiotische Pflege in meine Routine?
Sanft reinigen, dann die probiotische Pflege (zum Beispiel Lipid Care) auftragen. Medizinische Produkte vom Arzt können davor zusätzlich genutzt werden. Wichtig ist die konsequente tägliche Anwendung, besonders in stabileren Phasen zwischen Schüben.
8. Empfehlung
- Probiotische Hautpflege: Wie Milchsäurebakterien bei Neurodermitis helfen – Lanbiotic GmbH
- Cortison bei Neurodermitis: Nebenwirkungen verstehen und minimieren – Lanbiotic GmbH
- Neurodermitis-Cremes: verträgliche Inhaltsstoffe im Überblick – Lanbiotic GmbH
- Forschung: Hautmikrobiom & probiotische Pflege – Lanbiotic GmbH